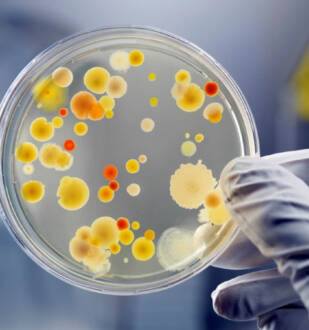

Түркияда Абай саябағы ашылды
Түркияның Чорум қаласында Абай саябағы ашылды. Жақсы хабарды бүгін Қазақстанның Түркиядағы елшілігі Facebook парақшасына жариялады. – Қазақтың Ұлы ойшылы, ақыны Абай Құнанбайұлы бабамыздың 175 жылдық мерейтойына…
Облыста мемлекеттік қызметте меритократиямен өсу үш есе артты
Өңірлік коммуникациялар қызметінің хабарлауынша, бұл туралы облыс әкімі аппаратының Әдеп жөніндегі уәкілі мәлімдеді.⠀ – Мемлекеттік қызметтегі меритократия – уақыт талабы. Бұл қағида қашанда мемлекеттік органдарға қабылдану…
Тұрғындар шағымы бойынша жұмыстар 1 аптада реттелмек
Махамбет ауданының әкімі Жәрдемғали Ахметов Сарайшық ауылындағы тұрғын үйлерде туған мәселеге түсінік берді. Бұл туралы Атырау облыстық коммуникациялар қызметі хабарлады. ⠀ Спикердің айтуынша, Махамбет ауданы тұрғындарын…
Биыл қазақстандықтар ғаламтордан не іздеді?
Google қазақстандық интернет пайдаланушылардың 2020 жылы ең көп іздеген сұрауларының рейтингін ұсынды. Қазақстандықтарды қызықтырған сұраулардың көшін «коронавирус» сөзі бастап тұр. Ең көп ізделген сұраулар: 1. Коронавирус…
Демалыс күндеріне ауа-райы болжамы жарияланды
«Қазгидромет» РМК 26–28 желтоқсанға арналған ауа-райы болжамын жариялады. Елімізге солтүстіктен ойысып келген арктикалық циклон Қазақстанның солтүстік және шығыс бөліктерінде ауа температурасының күрт төмендеуіне әкеліп соғады. Сынап…
Нигерияда коронавирустың жаңа түрі пайда болды
РИА Новостидің хабарлауынша, бұл туралы Африкалық кеңес жанындағы Африка ауруларды бақылау және алдын алу орталығындағылар мәлімет таратқан. – Біз Нигерияда анықтаған жағдай әзірше деректердің шектеулі көлеміне…
Кеше өңірде 62 адамнан КВИ анықталды
Атырау облысында өткен тәулікте 62 адамнан коронавирус індеті ПТР арқылы анықталды. Бұл туралы Атырау облыстық денсаулық сақтау басқармасының баспасөз қызметі хабарлады. Қауіпті дертке шалдыққан науқастардың 12-сі…
Облыста қылмыс деңгейі төмендеуде
Бұл туралы Атырау облыстық полиция департаменті хабарлады. Пандемиялық жағдайға байланысты, жалпы еліміздегідей, біздің өңірде де қылмыс саны төмендеген. Мәселен, облыс аумағында жүргізілген жедел және профилактикалық шаралар…
Есірткі сататын 38 сайт бұғатталды
Заманауи технологиялардың дамуымен, қылмыскерлер өз әрекеттеріне өзгелерді тарту үшін интернет желілерін және басқа да байланыссыз мүмкіндіктерді белсенді түрде қолданануда. – Мысалы, соңғы жылдары психобелсенді заттар мен…
Cауда орталықтарының жұмысы тоқтамайды
Атырау базарлары мен сауда орындары Атырау облысының Бас мемлекеттік санитариялық дәрігерінің қаулысына сай жұмыстарын істей береді. Бұл туралы Атырау облыстық коммуникациялар қызметі хабарлады. Кей әлеуметтік желіде:…